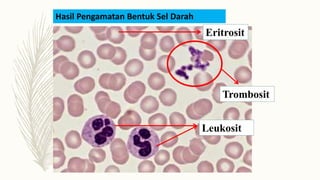
Hasil Pengamatan Bentuk Sel Darah
Trombosit
Leukosit
Eritrosit

Sistem peredaran darah manusia terdiri atas sistem peredaran darah tertutup dan ganda dimana darah mengalir dalam pembuluh darah dan melewati jantung dua kali dalam satu siklus peredaran. Sistem ini berfungsi untuk menjaga suhu tubuh, transportasi zat gizi dan limbah, perlindungan, serta penyangga asam-basa darah. Darah terdiri atas plasma, eritrosit, leukosit, dan trombosit yang memainkan peran penting dalam fungsi